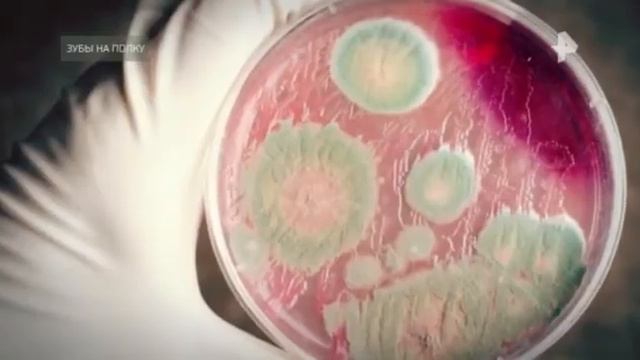
ТАЙНЫ ЧАПМАН 05 10 2020 смотреть онлайн

Автор / Канал: Урановские приключения

Казахстан поздравили с Днем Независимости

Neptune with Sub Titles

25 января 2022 г.

Planet Rock (Rerecorded Remix #3)

Saturn with DBK21 camera

Anyone know this song in the background from episode 3 on sifi's Resident Alien? shazam doesnt.

ФИГАЧИМ 10% В ДЕНЬ С ТОП АДМИНОМ! #заработок #инвестиции #фастхайп

Boss suites nana hotel view by indian part 2

Martian dance

Тебе срочное сообщение!✨️ Лови удачу!💥💞💌 #знаки_вселенной #shorts #мечта #сила #победа #успех

продолжаем играть в игру затмение

MeatKilla - Космическая любовь

Юпитер 5

Gaga - Курим ✵♛

Top 5 DevSecOps Tools of 2022

Наваливаем по полной загоняя сердечные ритмы в космос

15 октября 2018 г.

VID 20141214 123218

Продали герефордов, отбивка скота

дождь в Ильичевске
ТАЙНЫ ЧАПМАН 05 10 2020

Код гармонии для нашей планеты Земля и всего Мироздания.

Memories of Mars - Dev Diary 01 - The Cloning Facility

корабль нло захватил Китай и Россию
За каждым успешным каналом стоит личность, идея и сотни часов кропотливого труда. Если вы здесь, значит, автор «Урановские приключения» уже сумел зацепить ваше внимание своим уникальным стилем или подачей. А мы на RUVIDEO позаботились о том, чтобы вы могли изучить весь архив его работ в максимально комфортных условиях — без лишней суеты и преград.
Почему за работами канала «Урановские приключения» так интересно наблюдать? Всё просто: это честный контент, который находит отклик в сердцах зрителей. На нашем ресурсе вы можете смотреть онлайн все видео любимого автора бесплатно и в хорошем качестве. Нам важно, чтобы вы видели каждую деталь и слышали каждый нюанс, поэтому мы используем только стабильные плееры из открытых источников Rutube.
Следите за новинками канала, пересматривайте старые шедевры и открывайте для себя новые грани творчества «Урановские приключения». Мы постоянно обновляем ленту, чтобы у вас под рукой всегда были самые свежие выпуски. Никаких сложных регистраций — только вы и творчество, которое вдохновляет. Приятного вам путешествия по миру авторского контента на RUVIDEO!
Видео взято из открытых источников Rutube. Если вы правообладатель, обратитесь к первоисточнику.